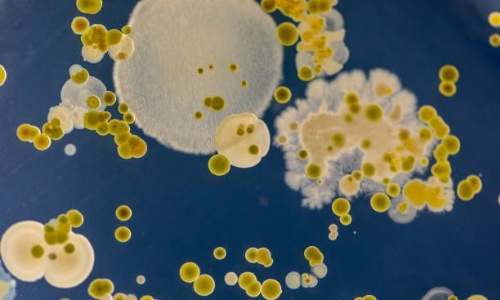

Harry E: I have really enjoyed reading The Viewer in our English lessons this week. The story asks more questions than I thought, and I am interested in exploring it's meaning.
Connie: This week I enjoyed Science where we had to find out the best conditions for growing yeast. We set up an experiment and observed the results over time. We found out that yeast grew best in warm water with sugar added.
Ivy: I am really enjoying NFL. We are working in teams to practise our game play and I like the 'strategy' behind the game.